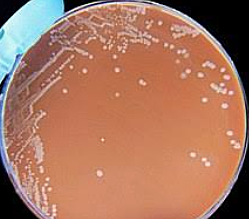
Secuenciación genoma Haemophilus influenzae

-
Mendel establece las bases de la genética con sus investigaciones con plantas de arveja
-
 Walter Sutton y Theodor Boveri establecen la Teoría cromosómica de la herencia por paralelismos con las leyes de Mendel.
Walter Sutton y Theodor Boveri establecen la Teoría cromosómica de la herencia por paralelismos con las leyes de Mendel. -
 Thomas Morgan confirmó la teoría cromosómica de la herencia en Drosophila melanogaster para el gen que determina el color de ojos, concordando con las leyes de Mendel y la teoría cromosómica de la herencia En organismos eucariotas cada especie tiene un numero característico de cromosomas (2n)
Thomas Morgan confirmó la teoría cromosómica de la herencia en Drosophila melanogaster para el gen que determina el color de ojos, concordando con las leyes de Mendel y la teoría cromosómica de la herencia En organismos eucariotas cada especie tiene un numero característico de cromosomas (2n) -
 Frederick Griffith descubrió el “Principio transformante” al experimentar con Streptococcus pneumoniae
Frederick Griffith descubrió el “Principio transformante” al experimentar con Streptococcus pneumoniae -
Se da el inicio de la era de la biología molecular con el estudio de ácidos nucleicos y proteínas
-
 Hershey-Chase utilizaron los radioisótopos 32P y 35S. Para determinar la composición del cromosoma
Hershey-Chase utilizaron los radioisótopos 32P y 35S. Para determinar la composición del cromosoma -
Basados en los datos de Rosalind Franklin, Watson & Crick postularon el modelo de la doble hélice
-
Margaret O. Dayhoff describió la secuencia de la insulina bovina, un pequeño péptido de 51 aminoácidos
-
ARNt que descodifica un codón de alanina en Saccharomyces cerevisiae
-
Margaret Dayhoff creó la primera base de datos de secuencias biológicas, en la cual almacenó y puso a disposición de la comunidad científica todas las secuencias de ADN y proteínas descritas hasta la fecha
-
Esta base de datos surgió inicialmente con el propósito de almacenar las estructuras proteicas determinadas por cristalografía de rayos X.
-
Margaret Dayhoff genera la primera matriz de substitución de aminoácidos, denominada PAM (Point Accepted Mutation)
-
lanzó el grupo de noticias BIOSCI/Bionet que fue uno de los primeros proyectos de la comunidad bioinformática en Internet, y cuyo fin era la promoción de comunicaciones libres entre biocientíficos
-
Temple Smith y Michael: Permitió optimizar la comparación de secuencias biológicas a lo largo de un alineamiento.
-
-
La reacción en cadena de la polimerasa fue desarrollada en 1983 por el Doctor Kary Mullis.
-
-
-
operaba como motor de búsqueda de secuencias similares dentro de la base de datos GenBank
-
-
implementación del algoritmo BLAST (Basic Local Alignment Tool) revolucionó completamente la exploración y búsqueda de secuencias biológicas en bases de datos
-
consorcio para la ejecución del proyecto de secuenciación del genoma humano (Human Genome, HUGO),
-
-
S. cerevisiae fue el primer genoma eucariota secuenciado.
-
se secuencia el genoma completo
-
Secuenciación genoma completo
-
se finalizó la secuencia definitiva del genoma humano y, este hecho se logró gracias a la proyección y explotación del potencial de la industria biotecnológica.
-
Illumina ha permitido la secuenciación masiva
-
Herramienta basada en una nueva, abierta, libre y cumpliendo
con una arquitectura documentada -
La base de datos de genomas eucariotas más completa, ENSEMBL (http://www.ensembl.org), cuenta con más de 50 genomas completamente secuenciados y anotados
-
Web Service con una arquitectura basada en la plataforma
(GITIRBio) que actúa como un sistema front-end distribuido para procesamiento autónomo y asistido por tuberías paralelas bioinformáticas
Simplifica la complejidad y cantidad de datos analizados obtenidos a
partir de la bioinformática, con el fin de mejorar y optimizar los procesos de decisión. -
Mediante diferentes programas se puede simular en el ordenador el acoplamiento entre la molécula de la diana y la del fármaco o compuesto que se quiere evaluar como posible fármaco. Esta técnica, conocida con el nombre de Docking, nos permite predecir si el fármaco se va a unir o no de forma efectiva a su diana, su eficacia “in silico”, de forma que se descartan los que previsiblemente no se van a unir y se priorizan los que sí.
-
Se utilizan diferentes programas para analizar y comparar estas secuencias, aportando datos que permiten conocer las características del virus, el seguimiento de su evolución y propagación, su ciclo y maquinaria vital, la realización de estudios filogenéticos que ayudan a entender las similitudes y diferencias con otros virus, así como entender los mecanismos de entrada del virus en la célula e identificar opciones potenciales de intervención.
Plan projects on a visual timeline
Map milestones, phases, deadlines, and key events in one place so the sequence is easier to see and share. Timetoast is a timeline maker for work, school, research, and stories.